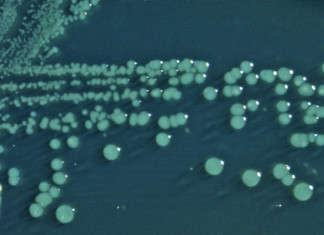

Método Aspire, un novedoso tratamiento para la obesidad y obesidad mórbida
Especialistas en tratamiento endoscópico de la obesidad realizan los primeros casos en España del Método Aspire, un novedoso tratamiento para la obesidad y obesidad...
Científicos descubren posible causa de la enfermedad de Alzheimer en el...
Si bien existe una creciente evidencia de que el sistema inmunitario está implicado en la enfermedad de Alzheimer, no está claro cómo. Ahora un...
La deficiencia de vitamina E podría dañar el cerebro
Los científicos han descubierto cómo la falta de la vitamina E podría causar daños al cerebro - por interrupción del suministro de nutrientes al...
Hombre ruso de 30 años de edad, es el voluntario en...
En febrero de Medical Press informó que un cirujano italiano anuncio planes para llevar a cabo el primer trasplante de cabeza humana en el mundo en...
Encontrado nuevo tratamiento para el cáncer de mama resistente
Los investigadores que investigan la forma en que el cáncer de mama HER2-positivo se vuelve resistente al tratamiento han hecho un descubrimiento sorprendente en...
El bronceado UV causa cáncer de piel, los médicos instan
Los médicos e investigadores que escriben en la revista American Journal of Preventive Medicine argumentan que es momento de empujar el mensaje de que...
Alcohol: ¿realmente trae beneficios para la salud?
A muchos de nosotros nos gusta una bebida con alchool o dos, sobre todo después de un duro día de trabajo. De hecho, algunos estudios han...
Shigella : una bacteria intestinal resistente a los medicamentos en difusión...
Un grupo de bacterias llamadas Shigella es responsable por mas de 500.000 casos de diarrea en los EE.UU. cada año. Ahora un nuevo informe dice...
Nuevos hallazgos apoyan los beneficios de comer nueces
Investigación sugieren que las nueces pueden tener el potencial de afectar positivamente varios factores importantes para la salud. A partir de su impacto en...
En los ratones con Alzheimer, memoria restaurada con medicamento contra el...
La memoria así como las conexiones entre las células cerebrales se restauraron en ratones con un modelo de un determinado medicamento experimental contra el...
Niño con autismo mejora su condición con antibiótico comun
Un padre de familia convence científicos a investigar las conexiones entre las bacterias del intestino y el autismo después de mejoras sorprendentes en el autismo de...
Descubierto mecanismo para detener el envejecimiento
La medicina ha mejorado, aumentando nuestra capacidad para tratar las enfermedades yw nuestra longevidad. El deterioro del cuerpo con la edad, sin embargo, es...